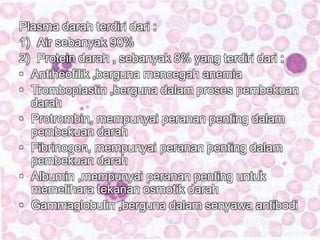
Plasma darah terdiri dari : 
1) Air sebanyak 90% 
2) Protein darah , sebanyak 8% yang terdiri dari : 
• Antiheofilik ,berguna mencegah anemia 
• Tromboplastin ,berguna dalam proses pembekuan 
darah 
• Protrombin, mempunyai peranan penting dalam 
pembekuan darah 
• Fibrinogen, mempunyai peranan penting dalam 
pembekuan darah 
• Albumin ,mempunyai peranan penting untuk 
memelihara tekanan osmotik darah 
• Gammaglobulin ,berguna dalam senyawa antibodi
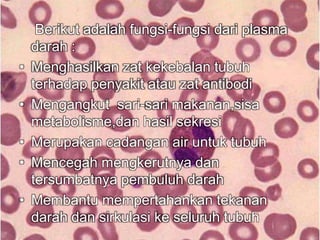
Berikut adalah fungsi-fungsi dari plasma 
darah : 
• Menghasilkan zat kekebalan tubuh 
terhadap penyakit atau zat antibodi 
• Mengangkut sari-sari makanan,sisa 
metabolisme,dan hasil sekresi 
• Merupakan cadangan air untuk tubuh 
• Mencegah mengkerutnya dan 
tersumbatnya pembuluh darah 
• Membantu mempertahankan tekanan 
darah dan sirkulasi ke seluruh tubuh
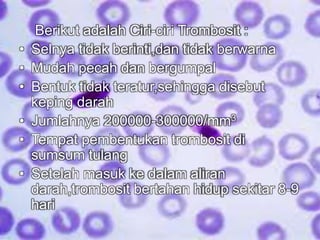
Berikut adalah Ciri-ciri Trombosit : 
• Selnya tidak berinti,dan tidak berwarna 
• Mudah pecah dan bergumpal 
• Bentuk tidak teratur,sehingga disebut 
keping darah 
• Jumlahnya 200000-300000/mm3 
• Tempat pembentukan trombosit di 
sumsum tulang 
• Setelah masuk ke dalam aliran 
darah,trombosit bertahan hidup sekitar 8-9 
hari
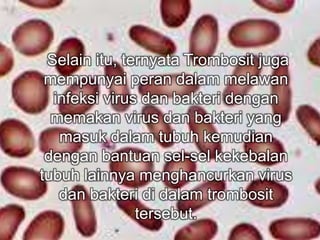
Selain itu, ternyata Trombosit juga 
mempunyai peran dalam melawan 
infeksi virus dan bakteri dengan 
memakan virus dan bakteri yang 
masuk dalam tubuh kemudian 
dengan bantuan sel-sel kekebalan 
tubuh lainnya menghancurkan virus 
dan bakteri di dalam trombosit 
tersebut.
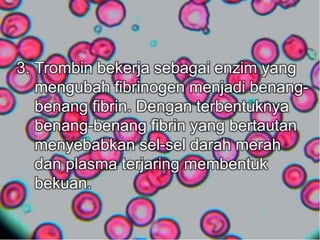
3. Trombin bekerja sebagai enzim yang 
mengubah fibrinogen menjadi benang-benang 
fibrin. Dengan terbentuknya 
benang-benang fibrin yang bertautan 
menyebabkan sel-sel darah merah 
dan plasma terjaring membentuk 
bekuan.

Plasma darah adalah cairan kuning yang menyertai sel darah dan mengandung protein, air, garam mineral, dan bahan organik. Plasma membantu proses pembekuan darah, mengangkut zat gizi, dan memelihara tekanan darah. Trombosit berperan dalam pembekuan darah dengan membentuk gumpalan di luka.